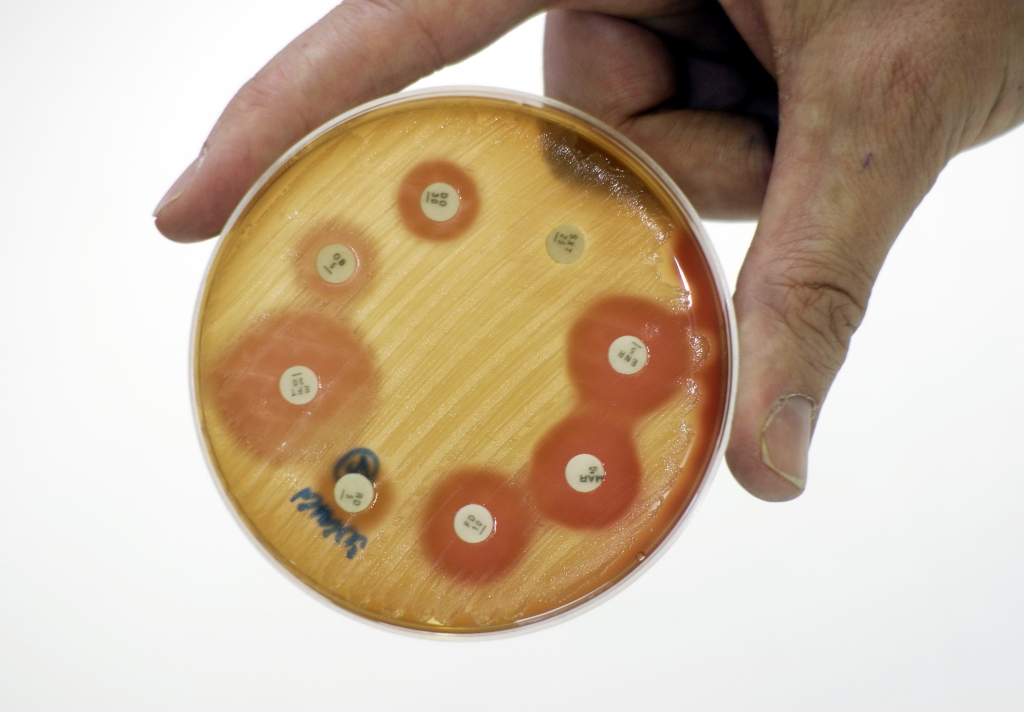

BEVA Journals Address The Role Of Equine Practice In The Downfall Of Antibiotics
Despite an investigation suggesting that by 2050, 10 million people might die annually because of antimicrobial resistance, public interest in the threat of the downfall of antibiotics appears limited, suggests Bruce Bladon, in the latest virtual issue of the Equine Veterinary Journal (EVJ). As guest editor of this issue, he has chosen 15 of the most pertinent articles on the topic from EVJ and its sister journal, Equine Veterinary Education. His intention is to highlight the significant risk resistance poses and the need to monitor and change equine practice protocols. The virtual collection is free to view here and marks Bruce’s recent appointment as president of BEVA.
In the United Kingdom, food animal veterinary antibiotic usage in terms of wholesale turnover, is monitored as part of the Veterinary Antimicrobial Resistance and Sales Survey, (VARSS). A target set in 2012 to reduce antimicrobial usage to below 50 mg per kg across all sectors was achieved in 2016. However, despite individual studies and surveys, there is no national data on antimicrobial usage within equine practice.
Three articles: Antimicrobial use and antimicrobial resistance in horses, Antimicrobial resistance in horses, a call to action and Room for improvement? The use of antimicrobials in equine respiratory disease present the background on current legislation, use and monitoring of antimicrobials in equine practice.
Audit of antimicrobial use in eleven equine practices over a five-year period (2014–2018) showed an impressive reduction in antibiotic usage but failed to accommodate the fact that the corporatised practices in the study may have been treating less horses. In addition, the withdrawal of a key antimicrobial from sale during the period had reduced antimicrobial usage figures.
Antimicrobial prescribing practice in UK equine veterinary practice and Antimicrobial prescribing and antimicrobial resistance surveillance in equine practice established that potentiated sulphonamides were the most frequently used class of antibiotic in equine practice and that there was a positive adoption of written antimicrobial usage policies. However, both also confirmed that the use of Highest Priority Critically Important Antimicrobials was frequent.
Use of antimicrobials licensed for systemic administration in UK equine practice reported the incidence of antibiotic prescription, to 19.5% (95% CI: 19.2%–19.8%) of 322 equids attended by UK veterinary practices in 2018. Category B antimicrobials were prescribed to 1228 equids (1.9%, 95% CI: 1.8%–2.0%). Active racehorses were 1.6 times more likely to receive antibiotics than non-racehorses.
Antibiotic use in first opinion equine practice in the United Kingdom: Serial point prevalence surveys in 17 practices Showed that Highest Priority Critically Important Antibiotic usage was similar, at 1.6% of consultations, with potentiated sulphonamides and oxytetracycline constituting two thirds of antibiotic prescriptions.
Antibiotic usage in 14 equine practices over a 10-year period (2012–2021) produced volumetric data compatible with the ESVAC and VARSS methodology. It showed that antibiotic usage did decline during the study period, from 60 to 46 mg/kg. A second metric, the Defined Daily Dose Veterinary per year was also reported, which was 1.52 in 2021, down from 1.7 in 2012.
Changing policy to treat foals with Rhodococcus equi pneumonia in the later course of disease decreases antimicrobial usage without increasing mortality rate reported on the treatment only of foals with larger abscesses. The authors documented a reduction in treatment of foals with rhodococcus pneumonia from 82% to 51% and reduction of median course duration from 41 to 23 days, associated with a statistically insignificant increase in all causes of mortality from 1.15% to 1.65%.
Standing equine cheek tooth extraction: A multivariate analysis of the effect of antibiotics on the risk of post-operative complications reported there was minimal difference in complication rates associated with antibiotic treatment versus extraction
performed without perioperative antimicrobial prophylaxis.
Surgical antimicrobial prophylaxis: Current standards of care reported on the extensive evidence-based guidelines in human surgery, which have been adapted to equine usage.
Post operative synovial sepsis following endoscopic surgery: Increased risk associated with the carpal sheath showed an identical rate of post-operative sepsis following arthroscopy without surgical antimicrobial prophylaxis compared to surgical antimicrobial prophylaxis.
Incidence and risk factors for complications associated with equine general anaesthesia for elective magnetic resonance imaging and Antimicrobial prophylaxis is not indicated for horses undergoing general anaesthesia for elective orthopaedic MRI provided contrasting results. This made it difficult to draw a conclusion about the need for peri-anaesthetic antimicrobials.
“Ultimately, the issue is reducing antimicrobial resistance, particularly in the human healthcare field,” said Bruce Bladon. “It is acknowledged that surgeon behaviour is a limiting factor in the adoption of appropriate surgical antimicrobial prophylaxis policies. Maybe if a clinician was persuaded that avoiding antibiotic prescription would reduce the incidence of antibiotic resistance, they might be more inclined to withhold prophylactic treatment.
“There is a need for a national surveillance programme. If you cannot measure it, you cannot manage it.”
The virtual issue can be found at https://beva.onlinelibrary.wiley.com/doi/toc/10.1001/(ISSN)2042-3306.antibiotics and will be free to view until 20 January 2025.
More from BEVA
- BEVA Congress applauds VNs with dedicated nursing stream
- Rising stars celebrated with BEVA One To Watch Award
- BEVA Reopens Popular Free Coaching Programme
- BEVA Congress 2026 to challenge how equine vets diagnose, treat and make decisions in practice
- BEVA Publishes Updated Guidelines for the Euthanasia of Insured Horses

 2 years ago
2 years ago  1410 views
1410 views
 5 days ago
5 days ago 